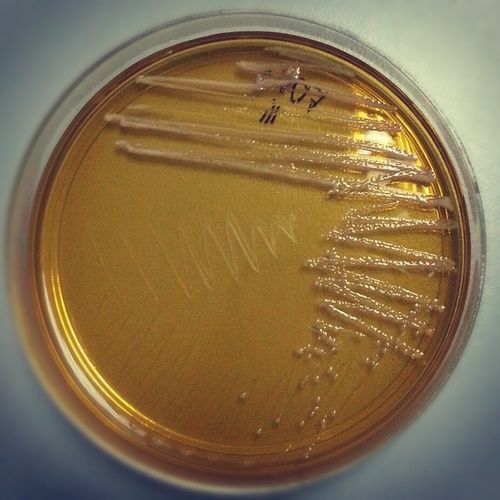
paijalhassan's profile picture. 🔬

Halimey Abu Bakar
@halimey
Ahli Dewan Negeri Selangor Seri Setia • Ketua Penerangan @KEADILAN Selangor • #4SeriSetia #SeriKekalSetiaBerbakti
You might like
Alhamdulillah, had pendapatan Skim Air Darul Ehsan (SADE) sekarang telah dinaikkan daripada RM5,000 kepada RM6,000 supaya lebih ramai keluarga terus dibantu dengan diberi air bersih percuma.Setiap tahun kos SADE mencecah RM52.7 juta. Bantuan air percuma disasarkan kepada mereka

Perasmian Pusat Khidmat Rakyat Parlimen #PetalingJaya pada hari ini telah dirasmikan oleh YAB @AmirudinShari, MB Selangor. Majlis turut diserikan dengan kehadiran ADUN Seri Setia @halimey, ADUN Taman Medan Syamsul Firdaus, ADUN Bukit Gasing @rajiv4malaysia,




Shahidan Kassim tanding DUN Selangor? PN ketandusan pemimpin di Selangor - @halimey
Saya & YB @halimey pergi ke Dewan Bunga Kertas di Taman TTDI Jaya untuk program sumbangan bakul makanan yang dikendalikan oleh Skuad Kebajikan Seri Setia. Seramai 80 keluarga telah menerima beg makanan daripada NGO Skuad Kebajikan Seri Setia.


Senamrobik anjuran Kementerian Belia & Sukan sempena Hari Wanita Sedunia di NZX Lembah Subang. Ramai penduduk turun berpeluh bersama @hannahyeoh , @AdamAdli , @halimey, Shatiri Mansor & @LimYiWei4MY.



Hampir 200 peserta program Pemantapan Penerangan KEADILAN Selangor dari seluruh negeri itu hadir terdiri dari 22 Biro Penerangan Cabang sebagai persediaan menghadapi PRN awal Julai nanti. @halimey

Sejuta penghargaan kepada YB Fahmi Fadzil diatas kesudian beliau merasmikan program Pemantapan Penerangan KEADILAN Selangor semalam anjuran penerangan negeri, NGO AMAN, Media Komunikasi Nasional dan Pusat Informasi Negeri Selangor. @fahmi_fadzil @halimey
(Video) "Wang Ehsan Kelantan & Terengganu akan disalurkan secara terus, digunakan untuk membantu golongan miskin tegar." - PM Anwar Ibrahim #Belanjawan2023 #MalaysiaMadani
Perebutan kerusi MB Selangor bukti PN tidak sepakat dlvr.it/SjHc54
Rumah Terbuka CNY bersama Pejabat Dun Seri Setia @halimey& Ahli Majlis Zon Tarikh : 12/2/2023 (Ahad) Masa : 10.30AM Lokasi : Parking Giant Kelana Jaya Ada beraneka jenis makanan, tarian tradisional Cina, tarian singa, nyanyian dan sebagainya. Jemput hadir beramai-ramai!

Ahli Dewan Negeri Seri Setia itu diundang merasmikan mesyuarat komuniti penduduk di Desa Mentari. #KitaSelangor #desamentari #halimeyabubakar #serisetia @halimey

MENU RAHMAH | Lebih 12,500 restoran mamak sahut gesaan kerajaan. Menu Rahmah ialah menu makanan nasi putih, berlaukkan ikan atau ayam dengan sayur bernilai RM5 ke bawah bagi golongan miskin tegar. @MyDSA_official @FuziahSalleh99 @KPDN_HQ #tv3
Jangan bertazkirah, fatwa sesuka hati. Islam tidak begitu, perlu diberi teguran - Anwar Ibrahim @anwaribrahim #MalaysiaMADANI #perpaduan
Penerangan Keadilan Selangor, Jabatan Penerangan Selangor jalin kerjasama sebar manfaat Iltizam Selangor Penyayang (ISP) iaitu 44 inisiatif kerajaan negeri kepada rakyat Selangor. @halimey @mazlihjsaring @rku454 @AmirudinShari @juezulkifli

Dato’ Menteri Besar Dato’ Seri Amirudin Shari berkata disebabkan itu Perdana Menteri Datuk Seri Anwar mahu wakil rakyat, menteri, kerajaan termasuk pembangkang menjayakannya. @AmirudinShari @anwaribrahim #KitaSelangor #MalaysiaMADANI

Rakyat Selangor tidak terpengaruh retorik Gelombang Hijau PN suarakeadilan.my/post/rakyat-se…
Untuk maklumat lanjut mengenai Skim Smart Sewa Selangor ❤️💛🇲🇾 boleh layari laman web phssb.com
Ada Skim Smart Sewa Selangor. Sewa utk 5 tahun, kemudian 30% sewa dipulangkan sbg deposit utk beli rumah. Selain itu Skim Biaya Selangor. Pembiayaan utk bayaran deposit rumah pertama. Boleh rujuk di LPHS
Kerajaan Negeri akan menanggung kos saringan, caj konsultasi pakar psikiatri, rawatan psikoterapi asas dan ubat-ubatan bagi dua minggu pertama untuk rawatan kesihatan mental. Insentif ini merupakan Selangor Mental Sihat (SEHAT) dengan peruntukan RM222,600. #KitaSelangor

Pelbagai aktiviti sampingan turut diadakan antaranya pertandingan sepakan tepat, cabutan bertuah, jualan jersi, kendera saji dan persembahan buskers. @pjcitycouncil @halimey

United States Trends
- 1. Alysa Liu N/A
- 2. Bloomington N/A
- 3. Punch N/A
- 4. Indiana N/A
- 5. Canada N/A
- 6. #LCDLF6 N/A
- 7. Cade N/A
- 8. Sony N/A
- 9. Bluepoint N/A
- 10. #PremioLoNuestro N/A
- 11. Megan Keller N/A
- 12. Toy Story 5 N/A
- 13. ariana N/A
- 14. Ley de Amnistía N/A
- 15. Celine N/A
- 16. Kaori N/A
- 17. Gold N/A
- 18. Aliens N/A
- 19. #inwx N/A
- 20. The Varsity N/A
You might like
-
 Demi Rakyat!
Demi Rakyat!
@Zaki_Yamani_ -
 AMK Malaysia
AMK Malaysia
@AMKMalaysia -
 Juwairiya Zulkifli 🇲🇾
Juwairiya Zulkifli 🇲🇾
@juezulkifli -
 Chang Lih Kang
Chang Lih Kang
@changlihkang -
 Pak Ya Tg Karang
Pak Ya Tg Karang
@yahyasahri -
 Julailey Jemadi
Julailey Jemadi
@nayeel -
 Azmizam Zaman Huri
Azmizam Zaman Huri
@Azmizam -
 Kyrilescobar#Rakyat#Haiwan
Kyrilescobar#Rakyat#Haiwan
@kyril_graguks -
 Syed Ibrahim 🇲🇾
Syed Ibrahim 🇲🇾
@syedibrahim_my -
 Naqib N. 🇲🇾
Naqib N. 🇲🇾
@Naqib2988 -
 Sidiqin Omar
Sidiqin Omar
@SidiqinOmar -
 Ramlan Roes 🇲🇾🏴
Ramlan Roes 🇲🇾🏴
@ramlanroes -
 Mohd Khuzzan Abu Bakar
Mohd Khuzzan Abu Bakar
@MohdKhuzzan -
 Ahmad Nazib Johari
Ahmad Nazib Johari
@nazibjohari
Something went wrong.
Something went wrong.